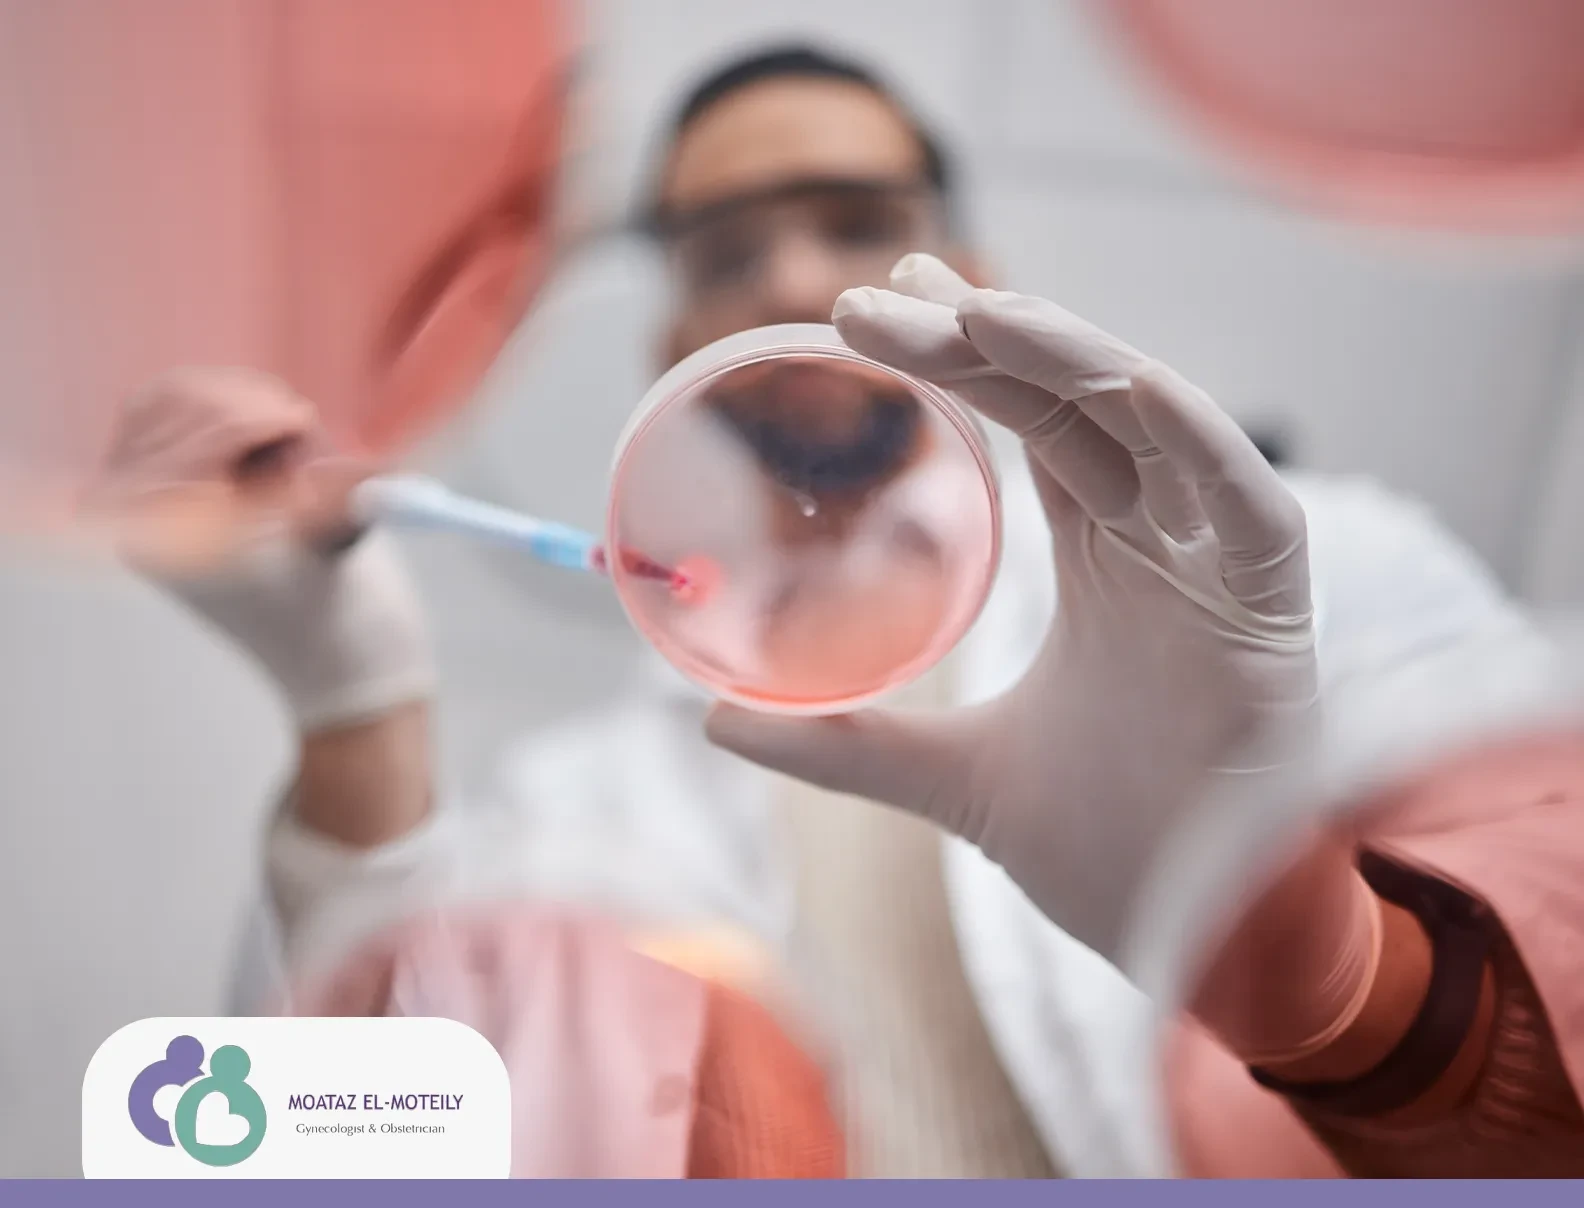
حقن تنشيط المبايض

حقن تنشيط المبايض
حقن تنشيط المبايض هي أدوية تستخدم لتحفيز المبايض على إنتاج بويضات ناضجة، مما يزيد من فرص الحمل، خاصةً لدى النساء اللواتي يعانين من مشاكل في التبويض. يتم استخدامها في علاجات الخصوبة تحت إشراف طبي لضمان الجرعة المناسبة ومتابعة الاستجابة.
ولذلك في هذا المقال سوف نتعرف على حقن تنشيط المبايض وأهمية هذه الحقن، كما سنتعرف على متلازمة فرط تحفيز المبيض، وذلك مع أحد المتخصصين في علاج مشكلات الخصوبة لدى النساء الدكتور معتز المطيلي - استشاري أمراض النساء والتوليد وعلاج تأخر الإنجاب والحمل الحرج وجراحات أورام النساء - فتابعوا معنا قراءة هذا المقال للنهاية لتتعرفوا على كافة التفاصيل.
معلومات هامة يجب معرفتها حول الإباضة
تبدأ الدورة الشهرية للأنثى كل شهر بعمل المبيض على إنضاج بويضة، وعند وقت التبويض، تخرج البويضة من المبيض في محاولة للقاء الحيوان المنوي لحدوث الإخصاب، وإذا لم يحدث الإخصاب، تستمر البويضة في الجسم لفترة قصيرة ثم تدخل الأنثى في مرحلة نزيف الدورة الشهرية، وهي عملية تحدث عادة كل 28 يومًا، مع احتمال أن تكون هذه الفترة أطول أو أقصر لدى بعض النساء، وفي حالات معينة قد يواجه المبيض صعوبة في إخراج بويضة ناضجة في توقيت مناسب، أو حتى في حالة إخراج بويضة ناضجة، قد تحتاج المرأة إلى مساعدة إضافية لضمان قدرة المبيض على أداء وظيفته بشكل صحيح، وهنا تبرز أهمية حقن تنشيط المبايض، والتي تُستخدم لتحفيز المبيضين على إنتاج بويضات ناضجة بطريقة فعالة؛ مما يعزز فرص الحمل ويعالج مشكلات التبويض.
ابدأي رحلتك نحو الأمومة اليوم! احجزي استشارتك مع مختصينا لمعرفة المزيد عن حقن تنشيط المبايض
ما هي حقن تنشيط المبيض؟
قبل التعرف على حقن تنشيط المبيض علينا أن نتعرف على عملية تنشيط المبيض نفسها، وهي عملية يستخدم فيها الطبيب أدوية تعمل على تنشيط المبيض، في النساء التي تُعاني من عدم انتظام الدورة الشهرية أو عدم حدوث دورة شهرية من الأساس فيما يُعرف بالعقم، والهدف من حقن تنشيط المبيض أو حتى أدوية تنشيط المبيض هي زيادة فرص الأنثى في الحمل والإنجاب سواء عن طريق العلاقة الحميمة أو حتى بالطرق التي تساعد في الإخصاب.
وحقن تنشيط المبيض هي حقن تحتوي على مواد تجعل الجسم يفرز هرمونات، وهذه الهرمونات تحفز أو تنظم عمية التبويض، وذلك يعني إنتاج بويضة من المبيض، كما يُمكن استخدام هذه الحقن أو الأدوية في الحالات التي تلجأ فيها الأنثى إلى طرق الإخصاب أو الحمل المختلفة منها أطفال الأنابيب أو الإخصاب المجهري، فإن أدوية تنشيط المبيض تساعد في إنتاج أكثر من بويضة لتُستخدم في هذه العمليات.
تجدر الإشارة إلى نقطة مهمة للغاية، وهي أن حقن تنشيط المبايض التي يُمكن أن تتسبب في الكثير من الآثار الجانبية مثل متلازمة فرط تحفيز المبيض، يوجد منها الكثير من الأنواع، وكل نوع يحتوي على هرمون مختلف، ولكن الأساس هي أن هذه الهرمونات تُنظم وتحفز المبيض لأداء وظيفته بأفضل طريقة ممكنة؛ ولذلك من الضروري اختيار أفضل الأطباء مثل الدكتور معتز المطيلي - استشاري أمراض النساء والتوليد وعلاج تأخر الإنجاب والحمل الحرج وجراحات أورام النساء - من أجل اختيار النوع المناسب لحالة الأنثى للحصول على أفضل النتائج.
هل توجد أدوية لتنشيط المبيض؟
من أكثر الأسئلة التي تسألها الإناث التي تُعاني من مشكلات المبيض، هل توجد أدوية لتنشيط المبيض؟ إذ تعتقد النساء أن هذه الأدوية هي حقن فقط، ولا يوجد حبوب أو أقراص يُمكن استخدامها في هذا الأمر.
لكن يمكن القول أنه يوجد العديد من الأدوية التي يُمكن استخدامها في تنشيط المبيض غير حقن تنشيط المبايض، وأشهر هذه الأنواع هي أقراص الكلوميد التي تُستخدم من فترات طويلة، وتُعطي نتائج رائعة، وغالبًا ما يستخدم الطبيب حبوب تنشيط المبيض وتحفيزه على الإباضة قبل اللجوء إلى حقن تنشيط المبيض، وفي حالة عدم الوصول إلى النتائج المرجوة باستخدام الحبوب فإن الطبيب يلجأ إلى الحقن من أجل علاج مشكلات المريضة.
متلازمة فرط تحفيز المبيض يُمكن أن تكون من الآثار الجانبية للحبوب مثلها مثل حقن تنشيط المبايض، لذلك من المهم الالتزام بكافة تعليمات الطبيب الخاصة بالجرعة والفترة التي يجب استخدام الحبوب فيها.
متى تحتاج المرأة لحقن تنشيط المبايض؟
توجد العديد من الحالات التي تلجأ فيها الأنثى إلى استخدام حقن تنشيط المبايض، وهذه الحالات تشمل:
-
أشهر الحالات هي النساء اللاتي تُعاني من مشكلات في التبويض، أي أنها تعاني من دورات شهرية غير منتظمة أو تتوقف لفترات طويلة، وتستخدم هذه الحقن لتحفيز المبيض على الإباضة وتنظيم الدورة الشهرية للأنثى.
-
الحالة الثانية الشهيرة لاستخدامات حقن تنشيط المبايض هي التلقيح الصناعي، إذ يحتاج الطبيب لإجراء هذه العمليات إلى عدد كبير من البويضات الناضجة، ولكن المبيض في الحالات الطبيعية يُنتج بويضة واحدة ناضجة كل شهر تقريبًا، ومن أجل الحصول على عدد من البويضات يمكن استخدام حقن تنشيط المبيض التي تحفز المبيض لإنتاج عدد كبير من البويضات الناضجة.
-
يمكن استخدام حقن تنشيط المبايض في علاج المشكلات التي تؤثر مباشرة على المبيض، وتُبطيء التبويض الطبيعي، وواحدة من أشهر هذه المشكلات هي متلازمة تكيس المبايض.
-
النساء اللاتي يمتلكن مستويات غير مناسبة من الهرمونات المسؤولة عن الدورة الشهرية مثل هرمون الـ FSH أو هرمون الـ LH، وهذه الهرمونات ضرورية من أجل التبويض والحمل بعد ذلك.
-
النساء اللاتي تُعاني من العديد من المشكلات الجسدية، التي تؤثر على عملية التبويض بطريقة غير مباشرة مثل مشكلات الغدة الدرقية أو اضطرابات الأكل والسمنة.
كل هذه الحالات تحتاج في الإناث إلى حقن تنشيط المبايض من أجل علاجها، وعلى الرغم من أن هذه الحقن ليست الحل الأول أو الوحيد لعلاج هذه المشكلات، لكن بعض الحالات تحتاج إلى هذه الحقن بالفعل للعلاج، كما أنها تُعد حلًا فعالًا وتعطي نتائج رائعة.
اقرأ عن
كم تستغرق عملية الحقن المجهري؟
الأعراض الجانبية لحقن تنشيط المبايض
على الرغم من كل فوائد حقن تنشيط المبايض، إلا أنه يوجد العديد من الآثار الجانبية التي تنتج عن استخدام هذه الحقن، وتؤدي هذه الآثار إلى العديد من الأعراض المزعجة التي تشمل:
-
الإصابة بالانتفاخ والشعور بالغثيان.
-
الصداع وصعوبة التنفس في بعض الحالات.
-
الشعور بهبات ساخنة، وهذا يُشبه بعض أعراض سن اليأس.
-
زيادة الوزن.
-
الشعور بألم في منطقة الحوض.
-
زغللة الرؤية.
تجدر الإشارة إلى أن كل الأعراض السابقة أو الآثار الجانبية السابقة هي أعراض لمتلازمة فرط تحفيز المبيض، والتي تُعد أشهر الآثار الجانبية لحقن تحفيز المبايض، وهي متلازمة تحدث عند زيادة استجابة المبيض للهرمونات الجنسية التي تتناولها الأنثى سواء حقن أو حبوب، كما أن متلازمة فرط تحفيز المبيض تتسبب في تورم المبيض وشعور الأنثى بألم شديد.
تجدر الإشارة إلى أن الأعراض السابقة بين الأعراض المتوسطة والشديدة، وغالبًا ما تختفي هذه الأعراض بعد عدة أسابيع من التوقف عن تناول هذه الأدوية، لذلك من المهم اختيار أفضل الأطباء عند اختيار حل حقن تنشيط المبايض، وذلك لتجنب كل الآثار الجانبية التي قد تحدث.
اعرف عن
علامات نجاح الحقن المجهري
متى يمنع استخدام حقن تنشيط المبايض؟
هل يمكن استخدام حقن تنشيط المبايض في كل الحالات؟ الإجابة قطعًا لا، إذ توجد العديد من الحالات التي تُعاني من بعض المشكلات والتي يُمنع فيها استخدام حقن تنشيط المبايض، وهذه الحالات أو المشكلات تشمل:
-
بطانة الرحم المهاجرة الشديدة.
-
انسداد قناتي فالوب.
-
حالات العقم غير معروفة السبب.
-
التاريخ المرضي بالإصابة بمتلازمة فرط تحفيز المبيض.
-
تشوهات الرحم.
-
اضطرابات الغدة الدرقية أو مشكلات الغدد غير المعالجة.
كل هذه الحالات السابقة لا يجب فيها استخدام حقن تنشيط المبايض، وذلك لأنها لا تُعطي النتائج المتوقعة وقد تتسبب في الكثير من المشكلات، لذلك من المهم اختيار أفضل الأطباء مثل الدكتور معتز المطيلي - استشاري أمراض النساء والتوليد وعلاج تأخر الإنجاب والحمل الحرج وجراحات أورام النساء - لتحديد الحالات التي تحتاج بالفعل إلى هذه الحقن.
في النهاية، توجد العديد من الحالات التي تحتاج إلى حقن تنشيط المبايض، ولكن على الجانب الآخر توجد بعض الآثار الجانبية مثل متلازمة فرط تحفيز المبيض، وبعض الحالات التي لا يجب استخدام هذه الحقن فيها، لكن الأهم من كل ذلك هو اختيار الطبيب المناسب للحصول على أفضل النتائج، لذلك لا تترددوا في التواصل مع عيادة الدكتور معتز المطيلي - استشاري أمراض النساء والتوليد وعلاج تأخر الإنجاب والحمل الحرج وجراحات أورام النساء - من أجل الحصول على أفضل النتائج من هذه الحقن.
مقالة قد تهمك
تكيسات المبايض وعلاجها
هل يحدث حمل بعد اخذ ابر تنشيط المبايض؟
تستخدم هذه الحقن في تنظيم الدورة وتحفيز المبيض وحل العديد من المشكلات، وبالتالي فإنها تزيد من فرصة الحمل بعد حل المشكلات التي تعاني منها الأنثى.
كم يزيد حجم البويضة مع ابر التنشيط؟
تساعد هذه الحقن في وصول البويضة إلى مرحلة النضوج، والتي تصل فيها إلى 18 إلى 22 مللي في الحجم.
كم نسبة نجاح ابر التنشيط؟
تمتلك حقن تنشيط المبايض نسبة نجاح عالية للغاية، وقد تصل نسبة النجاح لأكثر من 70% في أغلب الحالات.
